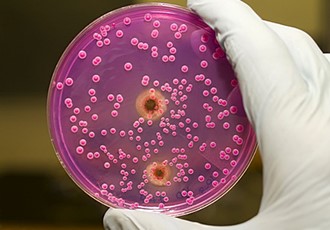

Причины возникновения грибковой ангины
Микроорганизмы, пребывающие в организме каждого человека, известны как условно-патогенные. Пока все системы функционируют нормально, они не причиняют вреда. Однако при нарушении иммунитета происходит усиление роста флоры и развитие воспалительных процессов.
У детей кандидозная ангина возникает из-за усиления роста грибков Candida (дрожжеподобные) и Aspergillus (плесневые). Основной причиной развития этого заболевания является нарушение баланса микрофлоры.
Факторы, способствующие возникновению грибковой ангины у детей, включают:
- неправильное, несбалансированное питание;
- продолжительное применение антибиотиков;
- низкий уровень гемоглобина;
- дефицит витаминов и минералов;
- присутствие хронических очагов воспаления в области носоглотки, включая придаточные пазухи;
- неправильный режим сна и активности, что может привести к повышенной утомляемости;
- сахарный диабет;
- ослабление местного иммунитета;
- применение гормональных препаратов, включая глюкокортикостероиды.
К рисковой группе относятся следующие категории людей:
- дети, которые родились недоношенными;
- дети, которые заразились грибковой инфекцией от больной матери, особенно это относится к детям, у которых мать заразилась молочницей, ВИЧ или другими венерическими заболеваниями во время беременности;
- дети, использующие общие игрушки, посуду и предметы быта;
- дети, находящиеся в контакте с носителем инфекции.
Малыши в раннем детстве чаще сталкиваются с ангиной из-за незрелой иммунной системы и низкой устойчивости организма. Если не оказать помощь вовремя, это может привести к развитию острого лимфаденита. Еще одним осложнением является переход патологии из острой формы в хронический кандидозный тонзиллит, который может сопровождать человека всю жизнь. При первых признаках заболевания важно немедленно обратиться за помощью.
Диагностика
Для установления точного диагноза врач-терапевт рекомендует пройти серию обследований. На основе полученных результатов анализов, специалист определяет наличие кандидозного тонзиллита. От точности постановки диагноза зависит эффективность лечения и продолжительность заболевания.
Инфекция кандидозного тонзиллита может быть легко спутана с молочницей во рту у новорожденного ребенка. Отличить грибковую инфекцию от фолликулярной ангины бывает сложно. Поэтому точный диагноз имеет важное значение, поскольку лечение грибковой ангины требует особого подхода.
Для определения наиболее эффективного курса лечения у детей врач советует пройти следующие обследования:
- Исследование горла с помощью фарингоскопии;
- Тестирование на аллергию на грибковые аллергены;
- Анализ на наличие возбудителя инфекции путем взятия образца из зева пациента для бактериологического посева.
Для уточнения состояния здоровья необходимо пройти общий анализ крови. При подозрении на смешанную инфекцию, врач может порекомендовать провести тест Фемофлор-Скрин. Проведение диагностики необходимо для исключения других возможных воспалительных процессов, таких как скарлатина, стоматит герпетического происхождения, сифилис или дифтерия.
Лечение грибковой ангины
Для лечения грибковой ангины педиатр назначает эффективные лекарственные препараты, основываясь на результатах анализов, характере заболевания и выявленных симптомах. Также можно применять народные методы лечения на основе лекарственных трав.
Для эффективного лечения ангины необходимо устранить причины, вызывающие воспалительный процесс в полости рта.
Медикаментозное лечение
Тонзиллит, вызванный грибковой инфекцией, возникает из-за размножения грибковых микроорганизмов. Первоочередное лечение включает введение противогрибковых препаратов (например, Нистатина, Флуконазола). Рекомендуется скорректировать лечение у детей, подобрав оптимальную схему приема и дозировку препаратов.
Для укрепления защитных сил маленького пациента в рацион вводят свежие фрукты и овощи, молочные продукты, а также пищу, богатую белками. Лечебный курс должен включать:
- Средства для дезинфекции горла, полоскания и увлажнения полости рта – Мирамистин, Гексорал, Тантум-Верде, Гивалекс, йодное покрытие;
- Препараты против грибковых инфекций;
- Комплексный курс витаминов С и группы В;
- Препараты для укрепления иммунитета – Имудон, Иммунал;
- Противомикробные препараты при бактериальной инфекции;
- Лечение физиотерапией;
- Препараты для снижения температуры – Ибупрофен, Панадол.
Для лечения заболеваний ротовой полости местного действия используются такие препараты, как Клотримазол, Кандибене и Кандид. Их следует применять, разводя раствор, и протирать полость рта 5 раз в день. Эти вещества эффективно воздействуют на пораженные участки слизистых оболочек.
Если в течение нескольких дней не наблюдается улучшения, врач приступает к применению системных лекарств. Эти препараты предназначены для борьбы с определенным типом грибковой инфекции (например, Дифлюкан, Микомакс).
При выявлении ангины у детей, лечение определяется исходя из симптомов. Важно начать лечебные мероприятия на ранних стадиях, поскольку это способствует более легкому и быстрому выздоровлению.
Народная медицина
Ангина легко передается от человека к человеку, особенно у детей, у которых она прогрессирует очень быстро. Важно ускорить процесс выздоровления, используя лечебные травы для дополнительного воздействия на полость рта.
Существуют специальные рецепты для лечения грибковой ангины у детей:
- Заготовки из листьев розы, череды, фиалки, хвоща. Высушенные травы заливаются горячей водой и настаиваются в течение 4 часов. После остывания проводить полоскание до 4 раз в день;
- Развести мед в воде, добавить сок лимона. Производить полоскание не менее 3 раз в день;
- Малиновое варенье или экстракт из малины – 1 ч.л. на стакан чая;
- Настой сока каланхоэ и прополиса. Смесью полоскать 3 раза в сутки, в течение 10 дней;
- Перец и мед — эффективно для детей старше 7 лет. 3 ст.л. меда и стручок красного перца помещаются в пергаментную бумагу, нагреваются и полученная смесь выливается в подготовленную банку. Подростку дают по 1 ст.л. 3 раза в сутки.
Лечение народными средствами способствует снижению воспаления, уменьшению отека и уменьшению количества вредоносных микроорганизмов при кандидозном тонзиллите. Травы, используемые в лечении, не вызывают нежелательных реакций, поэтому их безопасно применять детям различного возраста.
Какие последствия, если запустить кандиду в горле или лечить грибок неправильно
Если не проводить соответствующее лекарственное лечение, развитие клинических проявлений заболевания может иметь различные проявления. Наиболее часто нелеченный грибковый тонзиллит может вызвать следующие осложнения:
- поражение внутренних органов кандидозом;
- возникновение воспалительных процессов в лимфатических узлах шеи и подключичных областях;
- появление кожных проявлений кандидозного заражения, разрушение ногтей в случае попадания спор грибковой инфекции в область ногтевых валиков;
- проникновение спор грибковой инфекции в органы дыхательной системы, что может привести к развитию воспалительных процессов, аналогичных тем, что происходят в миндалинах;
- разрушение эмали зубов (особенно подвержены кариесу поверхности зубов, близкие к гландам).
Предсказать все возможные негативные последствия и осложнения, возникающие при запущенной форме кандидозного тонзиллита, является довольно сложной задачей. В данном контексте представлены основные риски и опасности, связанные с этим заболеванием.
Лечение грибковой ангины у детей
Для начала лечения грибкового ангинита следует обратиться к медицинскому специалисту. Важно не путать обычный бактериальный или вирусный тонзиллит с грибковым заболеванием. Лечение каждого вида ангины имеет свои особенности. Методы терапии у взрослых и детей при кандидозной ангине практически идентичны, различие заключается лишь в дозировке лекарственных препаратов.
Если у новорожденного младенца появился этот вид тонзиллита, то необходимо лечить и мать, и ребенка. Если не лечить мать, то малыш будет постоянно заражаться грибком. Кормящим женщинам важно тщательно следить за состоянием своей груди.
Если у ребенка старше возраста диагностирована грибковая ангина, следует обязательно учитывать необходимость соблюдения постельного режима в процессе лечения. Организм детей должен иметь достаточно времени для восстановления своих защитных сил. Также важно помнить о необходимости качественного, витаминизированного питания. Рацион должен быть насыщен белковой пищей, фруктами и овощами. Не рекомендуется употребление мучных изделий и сладостей, так как эти продукты способствуют размножению патогенных грибков. Пища должна быть мягкой и не содержать крупных и грубых частиц. Рекомендуется приготовление супов, бульонов и пюре.
Сохранение оптимального уровня воды в организме имеет важное значение. Рекомендуется употреблять несладкие компоты, морсы, свежевыжатые соки, а также несладкий чай.
Продукты с добавлением молочнокислых бактерий эффективно восстанавливают баланс микроорганизмов в кишечнике, что имеет важное значение для здоровья всего организма при нарушении бактериального равновесия.
В помещении, где находится пациент, необходимо поддерживать чистоту и оптимальный уровень влажности воздуха. Для этого необходимо регулярно проветривать помещение и убирать влажной уборкой. При сухом воздухе горло будет еще более подвержено пересушиванию, что может усилить негативные симптомы.
При рассмотрении лекарственных средств, особое внимание уделяется приему препаратов в лечении грибкового ангины:
- Препаратов против грибковых инфекций;
- Антисептических средств (для полоскания);
- Питательных веществ;
- Иммуномодуляторов.
Индивидуальные особенности пациента, его возраст и степень развития заболевания определяют выбор препаратов, их дозировку и продолжительность приема.
Лечение грибковой ангины
Лечение грибковой ангины требует особого подхода. Прежде всего, необходимо прекратить прием антибиотиков, которые могли вызвать нарушение микрофлоры. При длительном использовании антибактериальных препаратов для профилактики грибкового тонзиллита, рекомендуется одновременно принимать нистатин или флюконазол в профилактических дозах. Кроме того, для восстановления здоровой микрофлоры организма, важно включить в рацион кисломолочные продукты, общеукрепляющие средства и витамины.
Избавление от грибковой ангины включает в себя следующие этапы:
- использование антисептических противогрибковых средств, таких как «Мирамистин» или «Гексорал»;
- полоскание горла раствором иодинола, повидон йода или хинозола;
- лечение пораженных участков йодинолом, 5 % раствором нитрата серебра, раствором Люголя, или 2 % метиленовым синим или 2 % генциановым фиолетовым;
- повышенное потребление витаминов группы В и С;
- применение иммуностимулирующих препаратов;
- облучение неба и миндалин ультрафиолетовым излучением.
Лечение грибковой инфекции может быть достаточно эффективным с использованием препарата Итраконазол, который способен уничтожать грибок и предотвращать распространение инфекции по организму. В случаях тяжелого течения грибковой ангины может потребоваться внутривенное введение препарата Флуконазол, а при наличии запущенной стадии ВИЧ-инфекции может быть назначен сильнодействующий препарат, такой как Амфотерицин.
Для лечения пораженного грибковой инфекцией горла можно воспользоваться домашними средствами, такими как полоскание разбавленным раствором яблочного уксуса. Важно употреблять достаточное количество жидкости, а также включать свежие фрукты и овощи в ежедневный рацион. Для облегчения боли в горле рекомендуется проводить ингаляции и применять компрессы.
Для процедур полоскания горла также можно использовать отвар из каланхоэ или прополиса. Чтобы достичь желаемого эффекта, рекомендуется проводить полоскания трижды в день в течение 5 дней. Также можно воспользоваться медом, смешанным с соком лимона и разбавленным теплой водой. В качестве средства для полоскания пораженного горла применяют отвар из лекарственных растений: зверобоя, череды, ромашки, травы хвоща, цветов трехцветной фиалки и цветов почек сосны. Ингредиенты следует смешать, залить кипятком и настоять в течение 2-3 часов.
Для достижения максимальной эффективности в лечении грибковой ангины необходимо тщательно придерживаться указаний врача. Компетентное вмешательство медицинского специалиста является правильным шагом в направлении быстрого выздоровления.
Чем лечить грибковую ангину?
Грибковое воспаление миндалин чаще всего возникает в результате приема антибактериальных препаратов или кортикостероидов. Для излечения этого заболевания необходимо в первую очередь скорректировать дозировку антибиотика или выбрать аналогичный препарат. Иногда может потребоваться полное прекращение приема антибактериального средства. Для лечения грибкового тонзиллита рекомендуется применять комплексную общеукрепляющую терапию, витаминотерапию и иммунотерапию. В большинстве случаев проводится промывание пораженных миндалин растворами антимикотических средств, таких как нистатин, леворин или хинозол.
При выявлении признаков грибкового тонзиллита у многих возникает вопрос: «Как лечить грибковую ангину?» Прежде всего, необходимо следовать рекомендациям врача, а также применять методы народной медицины, включая полоскание горла отварами лекарственных растений. Среди других средств для домашнего лечения кандидозной ангины можно выделить:
- Чеснок обладает естественным антибактериальным свойством и ярко выраженным противогрибковым действием. Можно употреблять его в свежем виде или принимать капсулы.
- Йогурт (предпочтительно натуральный, с добавлением пробиотиков) способствует восстановлению нарушенной микрофлоры, что помогает снизить проявления грибковой инфекции.
- Масло чайного дерева. Добавьте несколько капель в стакан теплой воды и используйте для полоскания горла 2-3 раза в день по 2-3 минуты.
Для того чтобы не усложнять ход заболевания, рекомендуется избежать потребления сладостей (конфет, пирожных, мороженого) и сахара, так как это способствует дальнейшему размножению грибка Candida Albicans. Согласно некоторым медицинским экспертам, при кандидозной ангине следует ограничить употребление дрожжевых и соевых продуктов, яиц, арахисового масла, кофеинсодержащих напитков, а также продуктов с высоким содержанием вредных пищевых добавок. Питание должно быть сбалансированным, однако не стоит придерживаться слишком строгих диетических ограничений. В случае если, несмотря на соответствующую терапию, грибковая ангина переходит в хроническую и рецидивирующую стадию, может потребоваться хирургическое лечение.
Что такое грибковая ангина
Грибковая ангина у детей — это инфекционное заболевание, которое характеризуется воспалением небных миндалин. Прогрессирующий воспалительный процесс при грибковом тонзиллите способствует распространению инфекции на лимфатические образования, задние стенки глотки, язык и слизистую оболочку щек.
Существует три вида грибкового ангинита:
- Грибковый тонзиллит – это воспалительное заболевание, которое возникает на миндалинах у основания языка;
- Тонзиллофарингит – инфекция распространяется на область глотки и миндалин;
- Фарингомикоз – характеризуется образованием очагов воспаления на слизистой оболочке глотки.
Если не проводить лечение фарингомикоза, это может привести к развитию фарингомикоза, который со временем может превратиться в тонзиллофарингит. В таком случае возможны осложнения, ухудшающие состояние здоровья.
Микроорганизмы, которые всегда находятся в полости рта, вызывают кандидозную ангину. При негативном воздействии на организм ребенка они становятся активнее и увеличиваются в численности. Снижение общего иммунитета выступает в качестве фактора, способствующего развитию этого заболевания.
Длительное развитие грибковой инфекции характеризуется медленным процессом, не сопровождающимся острым воспалением. Дети чаще всего подвержены грибковой ангине. Если появляются первые незначительные симптомы, важно обратиться за медицинской помощью.
Причины развития грибковой ангины
Заражение грибковой ангиной происходит при воздействии обнаруженного гриппа, ОРВИ или бактериальной инфекции. Для грибковой ангины требуется определенное лечение. Если терапия проводится неправильно, то заболевание может прогрессировать в осложненную форму – тонзилломикоза или переходить в кандидозный тонзиллит хронического характера.
Одной из причин возникновения кандидозной ангины является дисбактериоз. Нарушение функционирования слизистых оболочек способствует развитию патологического процесса и увеличению количества патогенных бактерий фолликулярной ангины.
Определяются факторы, которые создают основу для развития патогенной микрофлоры и образования очагов кандидозной ангины:
- Недолеченные простудные заболевания, такие как ОРВИ, грипп, гайморит и синусит;
- Отсутствие необходимых питательных микроэлементов и витаминов в организме маленького пациента;
- Предварительное заражение серьезными инфекционными или вирусными заболеваниями;
- Недостаток витаминов, способствующих развитию гиповитаминоза;
- Переохлаждение носоглотки или всего организма ребенка;
- Приобретение хронического тонзиллита в раннем возрасте;
- Хроническая усталость у дошкольников, особенно при интенсивной физической или умственной нагрузке;
- Дисбактериоз пищеварительной системы;
- Продолжительное или неконтролируемое применение лекарственных препаратов у ребенка.
Множество детей находятся в зоне риска заражения фолликулярной ангиной. Существуют определенные категории, которые более подвержены этому заболеванию:
- Люди, столкнувшиеся с онкологическим заболеванием и прошедшие курс химиотерапии;
- Новорожденные младенцы;
- Дети в возрасте старше 7 лет и подростки, злоупотребляющие вредными привычками, такими как употребление алкоголя и курение;
- Дети, родившиеся преждевременно (недоношенные);
- Маленькие пациенты с выявленным врожденным или приобретенным сахарным диабетом;
- Дети, страдающие инфекциями полости рта (пародонтит, кариес);
- Младенцы, не получающие должного питания;
- У детей развитие грибковой инфекции происходит намного чаще, чем у взрослых, из-за несовершенного иммунитета.
Симптомы заболевания
В начальной стадии заболевания симптомы не проявляются, кандидозная ангина может протекать без каких-либо признаков. У ребенка не возникает болевых ощущений в горле или другого дискомфорта. Также отсутствует общая интоксикация и повышение температуры.
При поражении организма грибковой инфекцией проявляются определенные признаки, и специалист определяет лечение исходя из этих симптомов:
- Неприятные ощущения в горле и дискомфорт при приеме пищи или глотании. В отличие от вирусных или бактериальных инфекций, воспалительный процесс проявляется менее ярко;
- Появление белого или желтоватого налета на задней стенке горла. Он может образовываться на миндалинах, слизистой оболочке щек, десен, языка, неба или задней части горла. При удалении налета с помощью марлевого тампона возможно появление кровотечения из ранки;
- Изменение в ощущении вкуса;
- Неприятный запах изо рта;
- Головная боль;
- Общая слабость организма;
- Увеличение размеров лимфатических узлов;
При грибковой ангине у детей проявляются симптомы и требуется лечение при повышенной температуре до критических отметок 40 градусов. Острая фаза развития грибковой инфекции продолжается в течение первых 7-12 дней после обнаружения признаков заболевания.
Методы лечения
Учитывая факт, что грибковая ангина передается через воздушно-капельный путь, важно начать лечение сразу, чтобы предотвратить заражение других членов семьи. Для излечения этого заболевания применяется комплексный подход, направленный на устранение симптомов болезни и основной причины – ослабленного иммунитета. Для этой цели используются как медицинские препараты, так и методы нетрадиционной медицины.
Когда сбивать температуру
Повышение температуры при грибковой ангине встречается нечасто и обычно не превышает отметку в 37,7°С. Нет необходимости снижать такую температуру, поскольку ее наличие указывает на то, что организм успешно борется с инфекцией.
Однако при повышении температуры выше 38°С, организм начинает активно снижать ее, чтобы предотвратить обезвоживание и интоксикацию. Для этого рекомендуется применять препараты, способные снизить жар и улучшить самочувствие. Если ребенок заболел, для снижения температуры можно использовать Нурофен или детский Парацетамол, а для взрослых — Ибупрофен.
Медикаментозное
Для терапии применяются антимикотические препараты, которые подавляют размножение грибков и восстанавливают баланс микрофлоры. Обычно назначается препарат Итраконазол. Однако, при прогрессировании заболевания и наличии осложнений, проводится внутривенное введение препарата Флуконазола.
Помимо лекарств от грибков, также рекомендуется применение местного лечения. Это включает использование специальных растворов для обработки ротоглотки, которые помогают предотвратить присоединение бактериальной инфекции и снимают дискомфорт в горле. При грибковом воспалении горла назначаются препараты Мирамистин и Гексорал в качестве антисептиков.
Также рекомендуется увлажнять горло растворами Йодинола или Хинозола. Если наблюдается значительное поражение слизистых оболочек, то применяются препараты Люголь и Йодинол. Их применяют для обработки пораженных участков ротоглотки. В серьезных случаях используется ультрафиолетовое облучение неба и миндалин.
Для укрепления защитных функций организма, врачи рекомендуют применение иммуностимулирующих средств и следование специальной диете, богатой витаминами В и С.
Антибактериальные препараты редко применяются для лечения грибковых инфекций, поскольку они не оказывают эффекта на грибки. Применение антибиотиков необходимо лишь в случае развития бактериальной инфекции, когда рекомендуется использовать антибактериальные средства из группы пенициллинов или макролидов.
Народные средства
Для усиления эффекта лечения грибковой ангины медикаментами можно использовать также методы нетрадиционной медицины. Специалисты советуют промывать горло растворами яблочного уксуса и соды. Растворы приготавливаются по следующему принципу:
- с уксусом из яблок — 1 столовая ложка уксуса на один стакан теплой воды;
- с гашеной содой — 1 чайная ложка соды на один стакан теплой воды.
Для эффективного избавления от кандидоза ротоглотки часто применяют смеси трав, которые используются для приготовления растворов для полоскания. Для приготовления таких растворов обычно берутся следующие травы в равных пропорциях:
- цветок ромашки;
- календульные лепестки;
- зверобой в траве;
- бутон фиалки;
- растение хвоща.
Для приготовления смеси следует взять 1 столовую ложку сбора, залить стаканом кипятка и оставить настояться в течение 30 минут, затем процедить.
Для борьбы с грибковой ангиной можно применить эффективное средство, приготовленное из меда и сока лимона (смешайте стакан воды с 1 столовой ложкой меда и 1 столовой ложкой лимонного сока). Кроме того, для полоскания горла можно использовать настойку каланхоэ или прополиса (добавьте 1 чайную ложку настойки на стакан воды).
Для полоскания горла используйте теплый раствор не менее 5 раз в день. После этой процедуры не рекомендуется есть или пить в течение следующих 30 минут.
Использование народных средств для лечения грибковой ангины рекомендуется только взрослым. Применение их для лечения детей не рекомендуется, поскольку травы и пчелопродукты могут вызвать у малышей аллергическую реакцию.
Характерные симптомы
Когда у пациентов развивается тонзилломикоз, они начинают жаловаться на неприятные ощущения в горле, которые усиливаются при глотании. Также они испытывают общую слабость, головные боли и головокружения, повышение температуры тела (обычно до 38 градусов). Кроме того, возникает чувство першения в горле и малопродуктивный кашель.
Инфекция в гланды обычно длится около 7-10 дней. При правильном лечении пациент постепенно начинает выздоравливать после этого периода. Однако, если лечение было неполноценным или пациент игнорировал рекомендации врача, существует риск того, что заболевание станет хроническим.
Также следует отметить, что воспалительный процесс может распространиться на окружающие лимфатические узлы, которые увеличиваются в размере и становятся немного болезненными при ощупывании.
Когда речь идет о младенцах, они проявляют беспокойство, испытывают трудности со сном и отказываются от еды при заболевании миндалин грибковой природы. В таких случаях следует обратиться к врачу.
Как выглядит тонзилломикоз
Существенно понимать, как проявляется заболевание. Если воспаление ограничено поверхностными тканями, наблюдается увеличение кровоснабжения слизистой оболочки полости рта, на которой присутствует налет, имеющий прозрачную и плотную структуру
При более выраженном воспалительном процессе обнаруживаются интенсивные отложения в зонах патологии. Они представляют собой бляшки белого цвета, которые накрывают заднюю стенку глотки и небные миндалины. Такой клинический признак очень характерен и легко узнаваем на фотографиях пациентов.
Лечение грибкового тонзиллита
Для взрослых, лечение грибковой ангины назначается врачом после проведения диагностики и анализа результатов.
Исследования, необходимые для подтверждения диагноза:
- подробное исследование состава крови;
- отбор образца слизи из носа;
- анализ образца налета с миндалин;
- получение образца слюны.
Подробный анализ крови предоставляет информацию о наличии возможных сопутствующих заболеваний, а также о возможном наличии первичного воспалительного процесса.
Из отпечатков слизистой оболочки носа и слюны проводится ПЦР-анализ, который помогает определить различные виды микроорганизмов в полости рта и носоглотке.
Образец ткани с накоплением на миндалинах берется для посева на специальную питательную среду. В случае положительного результата на грибковую инфекцию, определяется вид и устойчивость к антибиотикам.
Осложнения заболевания
Часто встречающиеся осложнения:
- воспаление уха;
- воспаление гортани;
- гнойница;
- гнойник.
Неправильное лечение может быть опасным для воспалительных заболеваний ЛОР-органов. Грибковая инфекция, которая вызывает ангину, может распространиться на желудочно-кишечный тракт, внутренние органы и центральную нервную систему.
У детей осложнения от ангины, вызванной Candida albicans, часто приводят к инфицированию и воспалению уха – отиту. Это состояние тяжело переносится, сопровождается высокой температурой, ознобом и лихорадкой. Из ушной раковины может выделяться гнойная жидкость. Лечение вторичного заболевания без установления первопричины может привести к глухоте.
Чем лечить грибковую ангину?
Прежде всего, необходимо пройти 
Попытки самостоятельного лечения или лечения ребенка от грибковой ангины могут серьезно навредить вашему здоровью и здоровью малыша!
При возникновении воспаления, перед обращением к врачу, многие предпочитают использовать традиционные домашние средства. Среди них могут быть следующие:
- промывание горла смесью соли и соды;
- полоскание горла хлоргексидином;
- рассасывание кусочков корня имбиря, покрытых сахаром.
Эти процедуры не вызовут вреда здоровью, если у вас нет аллергии на используемые компоненты.
Использование лекарств разрешено только при назначении врача.
Грибковое поражение горла у детей требует предварительного вмешательства специалиста. Одним из методов лечения в этом случае является удаление налета в полости рта при помощи турунды, смоченной раствором хлоргексидина. Важно помнить, что самостоятельное применение лекарств перед постановкой диагноза и назначением лечения категорически не рекомендуется.
Определение причины заболевания может потребовать несколько дней, в течение этого времени врач назначит необходимое поддерживающее лечение.
Что это такое, в чем причины и отличия
Кандидозный тонзиллит возникает из-за поражения эпителиальных тканей миндалин грибками, которые проникают в клеточную структуру гланд и начинают размножаться внутри них, вызывая патологическое состояние.
В данном случае цикл жизни грибковой инфекции, которая атакует миндалины, основывается на том, что она получает питание из клетки, в которой обитает. Когда все питательные вещества исчерпаны, клетка гланд погибает, и затем грибковая инфекция начинает захватывать новые клеточные структуры.
Кандидозный тонзиллит имеет отличительную особенность от других форм этого заболевания: он редко переходит в острую фазу, сопровождаемую значительным повышением температуры тела, сильным болевым синдромом и другими признаками воспаления горла, которые характеризуются ярко выраженной симптоматикой. При грибковом тонзиллите воспаление в области гланд всегда протекает медленно и может продолжаться в течение нескольких лет без проявления острой формы заболевания. Причины возникновения кандидозного поражения миндалин связаны с наличием следующих факторов.
Неудовлетворительные бытовые условия
Удивительно, но 83% пациентов, обращающихся в медицинские учреждения с симптомами грибкового тонзиллита, проживают в домах с повышенной влажностью, что способствует размножению грибков различных видов. В процессе своего развития кандидозные микроорганизмы адаптируются к новым условиям и успешно распространяются в обновленных средах. В данном случае гланды становятся первой целью микозных организмов, так как они выступают в роли биологического фильтра, защищающего организм от проникновения вредных биологических агентов. Человеку достаточно вдохнуть споры грибковой инфекции, чтобы они осели на слизистой оболочке гланд и стали причиной заболевания.
Слабый иммунитет
Местная и общая защитная система организма защищает человека не только от бактерий и вирусов, но также от кандидозных микроорганизмов. В случае если у человека изначально ослаблен иммунитет, то рано или поздно грибковая инфекция может нанести ущерб его здоровью.
Частые заболевания горла
Поскольку пациенты часто подвергаются инфекционным и респираторным заболеваниям горла, их гланды постоянно находятся под напряжением, и со временем теряют свою нормальную функцию, что делает их более уязвимыми для грибковых инфекций.
Аллергия
Кандидозный тонзиллит может быть вызван аллергическими реакциями, так как под воздействием внешних раздражителей, на которые реагирует организм человека отеком и воспалением слизистой оболочки верхних дыхательных путей, клетки миндалин начинают работать иначе.
Их защитная функция была снижена, что привело к активному размножению грибковых микроорганизмов и охватыванию все больших участков поверхности гланд.
Вредные привычки
Употребление алкоголя, курение табака, употребление наркотиков и другие формы патологической зависимости, которые прямо влияют на физиологическое состояние организма больного, ослабляют местную иммунную систему в области горла, делая ее уязвимой перед грибковыми инфекциями.
Воздушно-капельный контакт
Для того, чтобы у ранее здорового человека внезапно начал развиваться кандидозный тонзиллит, необходимо непосредственно контактировать с источником микозных спор. Это могут быть предметы, на которых произрастает плесень или другие признаки наличия грибка, либо же достаточно поцелуя между человеком, носителем кандидозной инфекции, и здоровым партнером. В таком случае вероятность возникновения кандидозного тонзиллита достигает 79%.
В зависимости от того, какой образ жизни ведет пациент, столкнувшийся с грибковым тонзиллитом, его возраста, качества питания, соотношения часов тяжелых физических нагрузок и отдыха, возможно присутствие в жизни больного и других причинных факторов, выступающих в качества источника болезни.
Чем отличается кандидозная ангина от бактериальной
Внешние признаки кандидозной и бактериальной ангины очень похожи, однако между этими заболеваниями имеются определенные различия. В первом случае температура редко поднимается выше 37,7 градусов. Бактериальная ангина всегда сопровождается покраснением слизистой оболочки горла. Другие отличительные особенности этих форм заболевания:
- Внешний вид горла. Если речь идет о бактериальной форме заболевания, гнойники обычно образуются только на небных миндалинах, в то время как покраснение распространяется на небные дужки и мягкое небо. При грибковой форме ангины вся поверхность глотки покрывается грибковым налетом.
- Размер, область распространения и характер белого налета. При грибковой форме он имеет вид творога, в то время как при бактериальной форме проявляется в виде гнойников. В первом случае налет локализуется на языке, небе и миндалинах, а во втором – только на миндалинах. После удаления налета при грибковой ангине остаются кровоточащие ранки, в то время как при бактериальной ангине слизистая просто краснеет.
- Тяжесть протекания заболевания. Грибковая ангина обычно протекает менее тяжело по сравнению с бактериальной формой, боли в горле не такие сильные, а флегмона незначительная.
- Наличие определенных симптомов. Боль в горле может отсутствовать при тонзилломикозе. Воспалению подвергается чаще только одна миндалина, что не характерно для бактериальной формы, при которой присутствует двусторонняя локализация.

Как лечить грибковую ангину
Определить заболевание способен специалист отоларинголог при проведении визуального осмотра. Для выявления типа грибков, вызвавших воспаление, необходимо взять мазок с поверхности миндалин. При тяжелом течении заболевания проводится анализ крови.
Для ликвидации отравления необходимо обязательно придерживаться режима питья. Взрослому человеку рекомендуется употреблять не менее двух литров жидкости в день. В качестве напитков подойдут чай, отвар из сухофруктов, компот или негазированная вода.
В отличие от других форм тонзиллита, грибковая ангина не поддается лечению антибиотиками, поскольку они не оказывают влияния на грибок. Непроизвольное употребление таких препаратов может способствовать развитию заболевания.
Для лечения заболевания используются препараты противогрибковой терапии, такие как Нистатин или Флуконазол. Оптимальную дозировку и режим лечения определяет специалист после личной консультации, их выбор зависит от возраста пациента и места поражения организма.
Полоскания используются в комплексной терапии заболевания.
- раствор Фурацилина: 1 таблетка Фурацилина растворяется в 100 мл кипятка. Промывайте горло этим средством 3–4 раза в течение дня;
- содовый раствор: в 200 мл теплой воды растворяется чайная ложка соды. Процедуру следует проводить каждые 3–4 часа до улучшения состояния;
- настой коры дуба: одну чайную ложку дубовой коры заваривают стаканом кипятка. После остывания до комфортной температуры процедуру следует процедить. Можно проводить эту процедуру до 5 раз в день;
- настой цветов ромашки, листьев эвкалипта и дубовой коры: растительное сырье в равных количествах смешивают и заливают кипятком, после чего процеживают. Применять настой следует 3–4 раза в день.
Для смягчения симптомов рекомендуется применять антисептические средства для полости рта и горла, такие как Гексорал или Мирамистин. Они доступны в виде аэрозолей или таблеток для рассасывания.
Поскольку состояние иммунной системы играет важную роль в развитии заболевания, специалисты рекомендуют применение иммуностимуляторов. Кроме того, для улучшения эффективности лечения применяются витаминные комплексы.
В отличие от других видов тонзиллита, грибковая ангина не поддается лечению антибиотиками, поскольку они не оказывают воздействия на грибок. Неправильное использование таких препаратов может способствовать усугублению заболевания.
Для борьбы с тонзилломикозом можно использовать специальный раствор: в 1 миллилитре витамина В12 растворяют измельченную в порошок таблетку Нистатина 250 миллиграмм и тщательно перемешивают. Полученным средством обрабатывают пораженные участки 2–3 раза в день. Продолжительность лечения зависит от исчезновения симптомов заболевания.
Для успешного излечения грибковой ангины у взрослых и детей необходимо внести изменения в рацион, поскольку некоторые продукты могут способствовать развитию грибковой инфекции.
Из питания убирают следующие продукты:
- сладости от кондитеров;
- сочные и спелые фрукты;
- шоколадные лакомства;
- экзотические бананы;
- разнообразные бобовые культуры;
- выдержанные и плотные сорта сыра;
- питательные сушеные фрукты;
- хрустящие орехи;
- заправки для маринадов;
- ароматные копчености;
- пикантный соевый соус;
- высококачественный алкоголь.
Появление язв вызывает дискомфорт при глотании пищи. Чтобы уменьшить болевые ощущения, рекомендуется употреблять супы, пюре, жидкие каши. Температура пищи должна быть комнатной, чтобы не раздражать слизистую оболочку. Из рациона следует исключить соленые, острые и кислые блюда.
Для ликвидации отравления необходимо строго соблюдать режим питья. Взрослому человеку рекомендуется употреблять не менее двух литров жидкости в течение дня. В качестве напитков подойдут чай, отвар из сухофруктов, компот или негазированная вода.
Для взрослых и детей, страдающих от грибковой ангины, важно с самого начала обратить внимание на свой рацион, поскольку многие продукты могут способствовать развитию грибковой инфекции.
Если ваше состояние ухудшается, то рекомендуется оставаться в постели. Во время болезни необходимо уменьшить физическое и эмоциональное напряжение.
Диагностика грибковой ангины
Для того чтобы установить диагноз, необходимо обратиться к врачу отоларингологу или инфекционисту. Сначала врач проведет устный опрос о состоянии здоровья пациента. Родители должны сообщить, как долго наблюдаются негативные симптомы, были ли ранее случаи подобного заболевания, и какие методы лечения были использованы. После опроса врач проводит осмотр пациента, включая пальпацию миндалин и осмотр горла. При грибковом воспалении миндалин слизистая оболочка становится ярко-красной, а миндалины увеличиваются и приобретают отечный вид.
Если на слизистой оболочке появляется белый налет, напоминающий творог, то врач обязательно проводит взятие мазка из зева. Даже если налет незначительный, все равно стоит провести лабораторный анализ. Чтобы взять мазок из зева у ребенка, его нужно посадить на стул и попросить открыть рот. Кончик языка фиксируется шпателем, а стерильным ватным тампоном проводят по горлу. Взятый материал отправляют в лабораторию. Если ребенок слишком маленький, то родители берут его на руки. Одной рукой держат его корпус, а второй – голову. Ножки ребенка зажимаются между своими ногами.
Когда новорожденный ребенок заболевает, его просто плотно укутывают и берут мазок. Чтобы определить степень развития болезни и точно выявить причину заболевания, врач назначает общий анализ крови, мочи и мазок из носоглотки.
Частые вопросы
Какие симптомы характерны для грибковой ангины?
Грибковая ангина проявляется болезненностью горла, наличием белого налета на миндалинах, повышением температуры тела, а также неприятным запахом изо рта.
Каковы возможные последствия грибковой ангины для горла?
Последствиями грибковой ангины для горла могут быть ослабление иммунитета, развитие хронического тонзиллита, а также возможность распространения инфекции на соседние ткани и органы.
Полезные советы
СОВЕТ №1
Обратитесь к врачу для точного диагноза и назначения соответствующего лечения. Грибковая ангина требует специального подхода и применения антимикотических препаратов.
СОВЕТ №2
Следуйте рекомендациям врача относительно приема лекарств и процедур. Не прекращайте лечение досрочно, даже если симптомы улучшились.